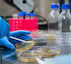

AECC de Cáceres celebra este viernes el Día Mundial de la Investigación en Cáncer
Con una serie de actividades que tendrán lugar este viernes, 22 de septiembre, en la calle San Pedro de Alcántara y el Quiosco de la Música.
21 September 2023 | Fuente: www.regiondigital.com
La Asociación Española contra el Cáncer (AECC) de Cáceres celebra el Día Mundial de la Investigación en Cáncer, que se conmemora cada 24 de septiembre.
Según la AECC, los investigadores españoles necesitan las mismas oportunidades que sus homólogos en otros países para superar el 70% de supervivencia en cáncer. Gracias a la investigación, la tasa de supervivencia es del 55,3% en hombres y del 61,7% y en mujeres por lo que, es clave garantizar que se investigue en todos los tipos de cáncer.
El acto del Día Mundial de la Investigación en Cáncer tendrá lugar a las 11,30 horas en la calle San Pedro de Alcántara de la capital cacereña y contará con la intervención del presidente de la AECC, Pedro Pastor Villegas; Santiago González Santiago, oncólogo del Hospital Universitario San Pedro de Alcántara; Encarna Solís, gerente del Área de Salud de Cáceres, y Jorge Suárez, concejal de Cultura del Ayuntamiento de Caceres.